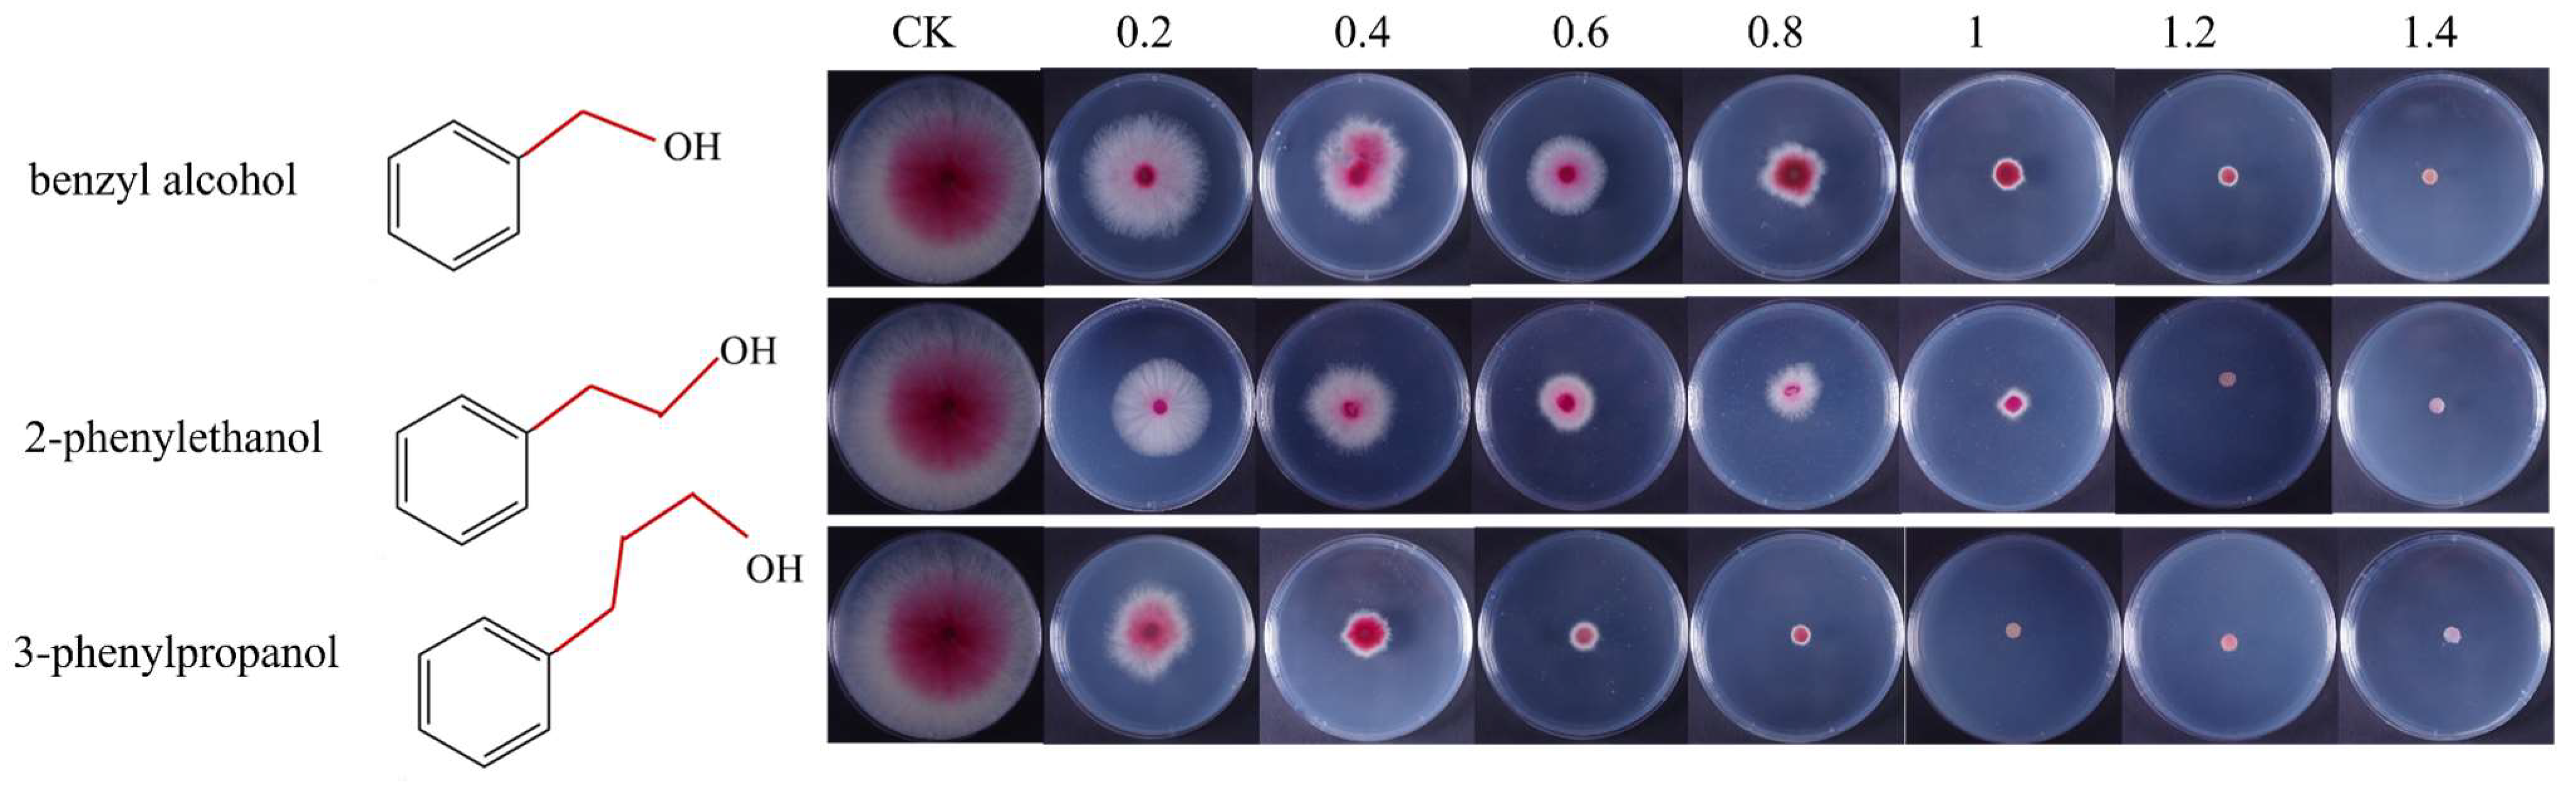
Microorganisms 11 02954 g006

Effects of 2-Phenylethanol on Controlling the Development of Fusarium graminearum in Wheat
Abstract
:1. Introduction
2. Materials and Methods
2.1. Fungicides and Plants
2.2. Chemicals
2.3. Gas Chromatography–Mass Spectrometry (GC-MS)
2.4. In Vitro Fungicidal Assay
2.5. In Vivo Fungicidal Assay
2.6. Metabolomics Analysis
2.6.1. Metabolite Extraction
2.6.2. UHPLC-Q-Exactive Orbitrap MS (UPLC-QE-MS) Analysis
2.6.3. Metabolomics Data Analysis
2.7. Determination of DON, 3ADON, 15ADON Content
2.8. Morphology and Ultrastructure of Fungal Hyphae
2.8.1. SEM Observation
2.8.2. TEM Observation
2.9. Antifungal Activity of Benzyl Alcohol, 2-Phenylethanol, and 3-Phenylpropanol
2.10. Statistical Analysis
3. Results
3.1. Detection of the 2-Phenylethanol in Wheat Spikes
3.2. 2-Phenylethanol Inhibits the Growth of F. graminearum In Vitro
3.3. Effect of 2-Phenylethanol on F. graminearum Growth In Vivo
3.4. Metabolomics Analysis of F. graminearum under 2-Phenylethanol Stress
3.5. 2-Phenylethanol Inhibited the Production of DON Toxin by F. graminearum
3.6. 2-Phenylethanol Changed the Ultrastructure of F. graminearum Mycelia
3.7. The Relationship between the Antifungal Activity and Length of the Carbon Chain
4. Discussion
Author Contributions
Funding
Data Availability Statement
Acknowledgments
Conflicts of Interest
References
- Jiang, C.; Hei, R.; Yang, Y.; Zhang, S.; Wang, Q.; Wang, W.; Zhang, Q.; Yan, M.; Zhu, G.R.; Huang, P.P.; et al. An orphan protein of Fusarium graminearum modulates host immunity by mediating proteasomal degradation of TaSnRK1α. Nat. Commun. 2020, 11, 4382. [Google Scholar] [CrossRef]
- Chen, Y.; Zhou, M.G. Characterization of Fusarium graminearum isolates resistant to both carbendazim and a new fungicide JS399−19. Phytopathology 2009, 99, 441–446. [Google Scholar] [CrossRef]
- Xu, M.; Wang, Q.H.; Wang, G.H.; Liu, H.Q.; Jiang, C. Combatting Fusarium head blight: Advances in molecular interactions between Fusarium graminearum and wheat. Phytopathol. Res. 2022, 4, 37. [Google Scholar] [CrossRef]
- Gilbert, J.; Haber, S. Overview of some recent research developments in fusarium head blight of wheat. Can. J. Plant Pathol. 2013, 35, 149–174. [Google Scholar] [CrossRef]
- Cuthbert, P.A.; Somers, D.J.; Brulé-Babel, A. Mapping of Fhb2 on chromosome 6BS: A gene controlling Fusarium head blight field resistance in bread wheat (Triticum aestivum L.). Theor. Appl. Genet. 2007, 114, 429–437. [Google Scholar] [CrossRef] [PubMed]
- Guo, J.; Zhang, X.L.; Hou, Y.L.; Cai, J.J.; Shen, X.R.; Zhou, T.T.; Xu, H.H.; Ohm, H.W.; Wang, H.W.; Li, A.F.; et al. High-density mapping of the major FHB resistance gene Fhb7 derived from Thinopyrum ponticum and its pyramiding with Fhb1 by marker-assisted selection. Theor. Appl. Genet. 2015, 128, 2301–2316. [Google Scholar] [CrossRef] [PubMed]
- Qi, L.L.; Pumphrey, M.O.; Friebe, B.; Chen, P.D.; Gill, B.S. Molecular cytogenetic characterization of alien introgressions with gene Fhb3 for resistance to Fusarium head blight disease of wheat. Theor. Appl. Genet. 2008, 117, 1155–1166. [Google Scholar] [CrossRef] [PubMed]
- Wang, M.O.; Bernardo, R.; Anderson, J.A. Validating the QTL for Fusarium head blight resistance in near-isogenic wheat lines developed from breeding populations. Crop Sci. 2007, 47, 200–206. [Google Scholar]
- Rawat, N.; Pumphrey, M.; Liu, S.; Zhang, X.F.; Tiwari, V.K.; Ando, K.; Trick, H.N.; Bockus, W.W.; Akhunov, E.; Anderson, J.A.; et al. Wheat Fhb1 encodes a chimeric lectin with agglutinin domains and a pore-forming toxin-like domain conferring resistance to Fusarium head blight. Nat. Genet. 2016, 48, 1576–1580. [Google Scholar] [CrossRef]
- Leroux, P. Chemical Control of Botrytis and Its Resistance to Chemical Fungicides. In Botrytis: Biology, Pathology and Control; Springer: Dordrecht, The Netherlands, 2007; pp. 195–222. [Google Scholar]
- Mendes, G.d.R.L.; Ponte, E.M.D.; Feltrin, A.C.; Badiale-Furlong, E.; de Oliveira, A.C. Common resistance to Fusarium head blight in Brazilian wheat cultivars. Sci. Agric. 2018, 75, 426–431. [Google Scholar] [CrossRef]
- Mair, W.; Lopez, F.R.; Stammler, G.; Clark, W.; Burnett, F.; Hollomon, D.; Ishii, H.; Thind, T.S.; Brown, J.K.M.; Fraaije, B. Proposal for a unified nomenclature for target-site mutations associated with resistance to fungicides. Pest Manag. Sci. 2016, 72, 1449–1459. [Google Scholar] [CrossRef] [PubMed]
- Ibtissem, B.A.; Hajer, B.S.; Ahmed, H.; Awatef, E.; Choumous, K.; Ons, B.; Mounir, Z.K.; Najiba, Z. Oxidative stress and histopathological changes induced by methylthiophanate, a systemic fungicide, in blood, liver and kidney of adult rats. Afr. Health Sci. 2017, 17, 154–163. [Google Scholar] [CrossRef] [PubMed]
- Gao, T.; Zhou, H.; Zhou, W.; Hu, L.; Chen, J.; Shi, Z. The fungicidal activity of thymol against Fusarium graminearum via inducing lipid peroxidation and disrupting ergosterol biosynthesis. Molecules 2016, 21, 770. [Google Scholar] [CrossRef]
- Arimura, G.I.; Ozawa, R.; Shimoda, T.; Nishioka, T.; Boland, W.; Takabayashi, J. Herbivory-induced voliates elicit defence genes in lima bean leaves. Nature 2000, 406, 512–515. [Google Scholar] [CrossRef]
- Mari, M.; Silvia, B.B.; Aharini, S. Decay control in the postharvest system: Role of microbial and plant volatile organic compounds. Postharvest Biol. Technol. 2016, 122, 70–81. [Google Scholar] [CrossRef]
- Liang, C.H.; Gao, W.T.; Ge, T.; Tan, X.W.; Wang, J.Y.; Liu, H.X.; Wang, Y.; Han, C.; Xu, Q.; Wang, Q.Q. Lauric acid is a potent biological control agent that damages the cell membrane of Phytophthora sojae. Front. Microbio. 2021, 12, 666761. [Google Scholar] [CrossRef] [PubMed]
- Dicke, M.; van Loon, J.; Soler, R. Chemical complexity of volatiles from plants induced by multiple attack. Nat. Chem. Biol. 2009, 5, 317–324. [Google Scholar] [CrossRef]
- Ma, D.C.; Wang, G.X.; Zhu, J.M.; Mu, W.; Dou, D.L.; Liu, F. Green leaf volatile trans-2-hexenal inhibits the growth of Fusarium graminearum by inducing membrane damage, ROS accumulation, and cell dysfunction. J. Agric. Food Chem. 2022, 70, 5646–5657. [Google Scholar] [CrossRef]
- Arctander, S. Perfume & Flavour Chemicals; Aroma Chemicals: Montclair, NJ, USA, 1969. [Google Scholar]
- Dai, J.; Xia, H.; Yang, C.L.; Chen, X. Sensing, uptake and catabolism of L-phenylalanine during 2-phenylethanol biosynthesis via the Ehrlich pathway in Saccharomyces cerevisiae. Front. Microbiol. 2021, 12, 601963. [Google Scholar] [CrossRef]
- Braga, A.; Mesquita, D.P.; Cordeiro, A.; Belo, I.; Ferreira, E.C.; Amaral, A.L. Monitoring biotechnological processes through quantitative image analysis: Application to 2-phenylethanol production by Yarrowia lipolytica. Process Biochem. 2023, 129, 221–229. [Google Scholar] [CrossRef]
- Masuo, S.; Osada, L.; Zhou, S.M.; Fujita, T.; Takaya, N. Aspergillus oryzae pathways that convert phenylalanine into the flavor volatile 2-phenylethanol. Fungal Genet. Biol. 2015, 77, 22–30. [Google Scholar] [CrossRef]
- Xu, H.X.; Li, Z.; Li, Y.L.; Cai, D.B.; Wang, Z.; Zhan, Y.Y.; Chen, S.W. Sustainable production of 2-phenylethanol from agro-industrial wastes by metabolically engineered Bacillus licheniformis. LWT 2023, 173, 114414. [Google Scholar] [CrossRef]
- Berrah, G.; Konetzka, W.A. Selective and reversible inhibition of the synthesis of bacterial deoxyribonucleic acid by phenethyl alcohol. J. Bacteriol. 1962, 83, 738–744. [Google Scholar] [CrossRef]
- Lucchini, J.J.; Bonnaveiro, N.; Cremieux, A.; Le Goffic, F. Mechanism of bactericidal action of phenethyl alcohol in Escherichia coli. Curr. Microbiol. 1993, 27, 295–300. [Google Scholar] [CrossRef]
- Huang, C.; Qian, Y.; Viana, T.; Siegumfeldt, H.; Arneborg, N.; Jespersen, L.L. The quorum-sensing molecule 2-phenylethanol impaired conidial germination, hyphal membrane integrity and growth of Penicillium expansum and Penicillium nordicum. J. Appl. Microbiol. 2020, 129, 278–286. [Google Scholar] [CrossRef] [PubMed]
- Ge, T.; Gao, W.; Liang, C.; Han, C.; Wang, Y.; Xu, Q.; Wang, Q. 4-Ethylphenol, a volatile organic compound produced by disease-resistant soybean, is a potential botanical agrochemical against Oomycetes. Front. Plant Sci. 2021, 12, 717258. [Google Scholar] [CrossRef] [PubMed]
- Thomulka, K.W.; Abbas, C.G.; Young, D.A.; Lange, J.H. Evaluating median effective concentrations of chemicals with bioluminescent bacteria. Bull. Environ. Contam. Toxicol. 1996, 56, 446–452. [Google Scholar] [CrossRef] [PubMed]
- Zhao, P.; Gu, S.; Han, C.; Lu, Y.; Ma, C.; Tian, J.; Bi, J.; Deng, Z.; Wang, Q.; Xu, Q. Targeted and untargeted metabolomics profiling of wheat reveals amino acids increase resistance to Fusarium Head Blight. Front. Plant Sci. 2021, 12, 762605. [Google Scholar] [CrossRef]
- Bai, G.H.; Kolb, F.L.; Shaner, G.; Domier, L.L. Amplified fragment length polymorphism markers linked to a major quantitative trait locus controlling scab resistance in wheat. Phytopathology 1999, 89, 343–348. [Google Scholar] [CrossRef]
- Han, Z.; Liu, X.; Ren, Y.; Luan, L.; Wu, Y. A rapid method with ultra-high-performance liquid chromatography–tandem mass spectrometry for simultaneous determination of five type B trichothecenes in traditional Chinese medicines. J. Sep. Sci. 2010, 33, 1923–1932. [Google Scholar] [CrossRef]
- Zhao, Y.T.; Yang, N.; Deng, Y.M.; Tao, K.; Jin, H.; Hou, T.P. Mechanism of action of novel pyrazole carboxamide containing a diarylamine scaffold against Rhizoctonia solani. J. Agric. Food Chem. 2020, 68, 11068–11076. [Google Scholar] [CrossRef] [PubMed]
- Hou, S.T.; Shi, H.B.; Zhang, H.; Wu, Z.B.; Hu, D.Y. Synthesis, Antifungal evaluation, 3D-QSAR, and preliminarily mechanism study of novel chiral mandelic acid derivatives. J. Agric. Food Chem. 2023, 20, 7631–7641. [Google Scholar] [CrossRef] [PubMed]
- De Walle, J.V.; Sergent, T.; Piront, N.; Toussaint, O.; Schneider, Y.J.; Larondelle, Y. Deoxynivalenol affects in vitro intestinal epithelial cell barrier integrity through inhibition of protein synthesis. Toxicol. Appl. Pharmacol. 2010, 245, 291–298. [Google Scholar] [CrossRef] [PubMed]
- Hsiao, T.H.; Kerkut, G.A.; Gilber, L.I. Comprehensive Insect Physiology Biochemistry and Pharmacology; Pargamon Press: Ocford, UK, 1985; pp. 471–512. [Google Scholar]
- Elsherbiny, E.A.; Amin, B.H.; Aleem, B.; Kingsley, K.L.; Bennett, J.W. Trichoderma volatile organic compounds as a biofumigation tool against late blight pathogen Phytophthora infestans in postharvest potato tubers. J. Agric. Food Chem. 2020, 68, 8163–8171. [Google Scholar] [CrossRef] [PubMed]
- Xu, Y.Q.; Tong, Z.C.; Zhang, X.; Wang, Y.Y.; Fang, W.G.; Li, L.; Luo, Z.S. Unveiling the mechanisms for the plant volatile organic compound linalool to control gray mold on strawberry fruits. J. Agric. Food Chem. 2019, 67, 9265–9276. [Google Scholar] [CrossRef] [PubMed]
- Yi, H.S.; Heil, M.; Adame-Alvarez, R.M.; Ballhorn, D.J.; Ryu, C.M. Airborne Induction and Priming of Plant Defenses against a Bacterial Pathogen. Plant Physiol. 2009, 151, 2152–2161. [Google Scholar] [CrossRef] [PubMed]
- Obara, N.; Hasegawa, M.; Kodama, O. Induced volatiles in elicitor-treated and rice blast fungus-inoculated rice leaves. Biosci. Biotechnol. Biochem. 2002, 66, 2549–2559. [Google Scholar] [CrossRef] [PubMed]
- Liu, P.; Cheng, Y.; Yang, M.; Liu, Y.; Chen, K.; Long, C.; Deng, X.X. Mechanisms of action for 2-phenylethanol isolated from Kloeckera apiculata in control of Penicillium molds of citrus fruits. BMC Microbiol. 2014, 14, 242. [Google Scholar] [CrossRef]
- Zou, X.; Wei, Y.; Jiang, S.; Xu, F.; Wang, H.W.; Zhang, P.P.; Shao, X.F. ROS stress and cell membrane disruption are the main antifungal mechanisms of 2-phenylethanol against Botrytis cinerea. J. Agric. Food Chem. 2022, 70, 14468–14479. [Google Scholar] [CrossRef]
- Lu, J.; Li, J.; Li, L.; Wang, Y.X.; Yang, S.; Xu, G.Y.; Dou, D.L.; Wang, X.D. Natural product 2-Phenylethanol inhibits ATP synthesis of P. infestans by blocking the oxidative phosphorylation pathway to prevent potato late blightf. Postharvest Biol. Tec. 2023, 199, 112310. [Google Scholar] [CrossRef]
- Majdabadi, N.; Falahati, M.; Heidarie-Kohan, F.; Farahyar, S.; Rahimi-Moghaddam, P.; Ashrafi-Khozani, M.; Razavi, T.; Mohammadnejad, S. Effect of 2-phenylethanol as antifungal agent and common antifungals (amphotericin B, fluconazole, and itraconazole) on Candida species isolated from chronic and recurrent cases of candidal vulvovaginitis. Assay Drug Dev. Techn. 2018, 16, 141–149. [Google Scholar] [CrossRef]
- Jones, O.A.H.; Maguire, M.L.; Griffin, J.L.; Jung, Y.H.; Shibato, J.; Rakwal, R.; Agrawal, G.K.; Jwa, N.S. Using metabolic profiling to assess plant-pathogen interactions: An example using rice (Oryza sativa) and the blast pathogen Magnaporthe grisea. Eur. J. Plant Pathol. 2011, 129, 539–554. [Google Scholar] [CrossRef]
- Nocek, B.P.; Gillner, D.M.; Fan, Y.; Holz, R.C.; Joachimiak, A. Structural basis for catalysis by the mono- and dimetalated forms of the dapE-encoded N-succinyl-L, L-diaminopimelic acid desuccinylase. J. Mol. Biol. 2010, 397, 617–626. [Google Scholar] [CrossRef] [PubMed]
- Shepherd, J.; Ibba, M. Direction of aminoacylated transfer RNAs into antibiotic synthesis and peptidoglycan-mediated antibiotic resistance. FEBS Lett. 2013, 587, 2895–2904. [Google Scholar] [CrossRef] [PubMed]
- Liu, X.; Han, Q.; Wang, J.; Wang, X.; Shi, J. Fgleu2a gene plays a crucial role in leucine biosynthesis and infection-related morphogenesis in Fusarium graminearum. Toxicon 2019, 158, S69. [Google Scholar] [CrossRef]
- Liu, X.; Han, Q.; Xu, J.; Wang, J.; Shi, J. Acetohydroxyacid synthase FgIlv2 and FgIlv6 are involved in BCAA biosynthesis, mycelial and conidial morphogenesis and full virulence in Fusarium graminearum. Sci. Rep. 2015, 5, 16315. [Google Scholar] [CrossRef]
- Audenaert, K.; Vanheule, A.; Höfte, M.; Haesaert, G. Deoxynivalenol: A Major Player in the Multifaceted Response of Fusarium to Its Environment. Toxins. 2014, 6, 1–19. [Google Scholar] [CrossRef]
- De Carvalho, C.C.; Caramujo, M.J. The Various Roles of Fatty Acids. Molecules 2018, 23, 2583. [Google Scholar] [CrossRef]
- Rupĕié, J.; Jurešié, G.Č. Influence of stressful fermentation conditions on neutral lipids of a Saccharomyces cerevisiae brewing strain. World J. Microb. Biotechnol. 2018, 26, 1331–1336. [Google Scholar]

| Compound | Regression Equation | R2 | EC50 (mg/mL) | 95% Confidence Interval |
|---|---|---|---|---|
| benzylalcohol | y = 1.837x − 0.687 | 0.973 | 0.374 | 1.358–1.960 |
| 2-phenylethanol | y = 2.20x − 0.071 | 0.970 | 0.328 | 1.898–2.501 |
| 3-phenylpropanol | y = 2.341x − 0.514 | 0.988 | 0.220 | 1.809–2.873 |
Disclaimer/Publisher’s Note: The statements, opinions and data contained in all publications are solely those of the individual author(s) and contributor(s) and not of MDPI and/or the editor(s). MDPI and/or the editor(s) disclaim responsibility for any injury to people or property resulting from any ideas, methods, instructions or products referred to in the content. |
© 2023 by the authors. Licensee MDPI, Basel, Switzerland. This article is an open access article distributed under the terms and conditions of the Creative Commons Attribution (CC BY) license (https://creativecommons.org/licenses/by/4.0/).
Share and Cite
Sun, S.; Tang, N.; Han, K.; Wang, Q.; Xu, Q. Effects of 2-Phenylethanol on Controlling the Development of Fusarium graminearum in Wheat. Microorganisms 2023, 11, 2954. https://doi.org/10.3390/microorganisms11122954
Sun S, Tang N, Han K, Wang Q, Xu Q. Effects of 2-Phenylethanol on Controlling the Development of Fusarium graminearum in Wheat. Microorganisms. 2023; 11(12):2954. https://doi.org/10.3390/microorganisms11122954
Chicago/Turabian StyleSun, Shufang, Nawen Tang, Kun Han, Qunqing Wang, and Qian Xu. 2023. "Effects of 2-Phenylethanol on Controlling the Development of Fusarium graminearum in Wheat" Microorganisms 11, no. 12: 2954. https://doi.org/10.3390/microorganisms11122954
APA StyleSun, S., Tang, N., Han, K., Wang, Q., & Xu, Q. (2023). Effects of 2-Phenylethanol on Controlling the Development of Fusarium graminearum in Wheat. Microorganisms, 11(12), 2954. https://doi.org/10.3390/microorganisms11122954

